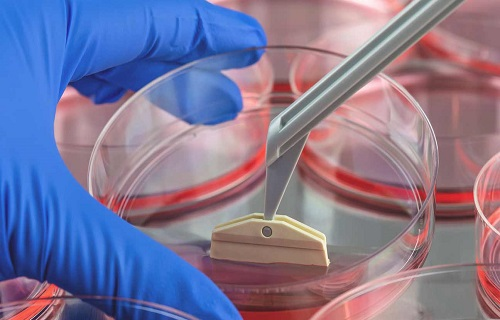

پزشکی بازساختی و فرصتهای پیش روی پژوهشگران ایرانی

تهران - ایرنا - پزشکی بازساختی به عنوان یکی از حوزههای جدید دانشی به سرعت درحال پیشرفت بوده و در یک دهه گذشته سرعت پرشتابی داشته است. اکنون با توجه به رقابت تنگاتنگی که در این حوزه در جهان و غرب آسیا وجود دارد و با توجه به نیاز حوزه پزشکی کشور ضرورت توجه به این حوزه بیش از پیش احساس میشود.
آرزوی ساخت اعضای بدن انسان یا ترمیم بافت ها و اندام ها، تاریخ دیرینه ای دارد و ردپای آن را می توان در افسانه های کهن و اسطوره های رم باستان یافت. پزشکی بازساختی از دیدگاه علمی شاخه ای جدید از پزشکی است که هدف آن بازسازی، ترمیم یا جایگزینی سلولها، بافت یا ارگان آسیب دیده یا از دست رفته بدن است. این شاخه از علم نوین پزشکی شامل بخشهای مختلف از جمله سلول درمانی، ژن درمانی، مهندسی بافت و درمان با سلولهای ایمنی میشود.
طب یاز پزشکی بازساختی به عنوان یکی از حوزه های جدید دانش پزشکی به سرعت در حال پیشرفت است و در یک دهه گذشته سرعت پرشتابی داشته است. این شاخه از علم پزشکی در سال های آینده نیز در درمان بیماری ها به ویژه بیماری های صعب العلاج و لاعلاج جایگاهی ویژه خواهد یافت.
در سال های اخیر این حوزه از علم مورد توجه دانشمندان و پزشکان قرار گرفته و بخش جداگانهای در منابع مرجع پزشکی به آن اختصاص یافته است.
هنگامی که زانو یا استخوانی می شکند یا بریدگی در پوست ایجاد می شود، بدن می تواند خود را ترمیم کند اما در مورد برخی بیماری ها مانند دیابت یا بیماری قلبی این گونه نیست. در طب بازساختی متخصصان به دنبال درمان ها و راهبردهایی شبیه آنچه که بدن خود را ترمیم می کند، هستند.
این شاخه از دانش پزشکی نخستین بار در دهه 1990 بر سر زبان ها افتاد؛ هنگامی که مهندسی بافت برای تحقیقات سلول های بنیادی و پیوند پوست مطرح شد. هدف از مهندسی بافت جایگزینی یا بازسازی بافت ها یا اندام های آسیب دیده در اثر بیماری، صدمه، بالا رفتن سن یا عوامل دیگر به جای درمان علایم با دارو و جراحی است.
بازسازی در بدن انسان در سه سطح رخ می دهد. بازسازی در سطح مولکولی شامل مولکول های کوچکی است که اجزای سازنده بدن انسان مثل دی ان ای، چربی و کربوهیدارت است، در سطح سلولی شامل ساختارهای سلولی نظیر نرون ها یا آکسون ها است که مسئول تکثیر و رشد سلول در بدن است و در سطح بافت که شامل خون، پوست، استخوان یا عضله می شود.
پزشکی بازساختی درآینده ای نزدیک صنعت پزشکی را دگرگون خواهد کرد و نویدبخش درمان بیماری هایی مانند سرطان، آلزایمر، پارکینسون، دیابت، بیماری های قلبی، نارسایی کلیوی، پوکی استخوان و آسیب طناب نخاعی می شود. هدف از این شاخه علمی یافتن درمان برای بیماری هایی است که زمانی غیرقابل معالجه بوده اند.
حوزه پزشکی بازساختی پنجرهای جدید در درمان بیماری ها گشوده است و با کمک یافته های جدید به دنبال درمان بیماری هایی است که پیش از آن جزو بیماری های صعب العلاج یا لاعلاج قرار می گرفتند. این حوزه یکی از مهمترین مباحث در پژوهشهای زیست فناوری است و امید میرود بسیاری از بیماریها با بهرهگیری از فناوری های نوین طب بازساختی درمان شوند.
امروز پژوهشگران تلاش می کنند با کمک یافته های جدید در زمینه علوم سلولی، مهندسی بافت، بیوتکنولوژی و مهندسی نانو و ترکیب آنها با علوم بالینی مانند پوست، ارتوپدی، جراحی بازساختی، دندانپزشکی بتوانند بدون استفاده از داروهای شیمیایی، درمان بیماران را به این سمت هدایت کنند.
در حال حاضر، مهندسی بافت به منظور ترمیم و جایگزینی بافت های فرسوده، به عنوان بهترین جایگزین پیوند عضو مطرح است. با مهندسی بافت، این قابلیت وجود دارد که از سلول های بدن خود بیمار برای ترمیم یا طراحی دوباره بافت فرسوده استفاده شود. در این حالت بسیاری از پیچیدگی های پیوند عضو نظیر مصرف طولانی مدت داروهای سرکوب کننده دستگاه ایمنی و خطرات رد پیوند حذف می شود.
دکتر مسعود وثوق مدیر گروه پژوهشی پزشکی بازساختی در پژوهشگاه رویان در این زمینه می گوید: پژوهشگاه رویان 32 سال پیش تاسیس شد. این پژوهشگاه در ابتدا مرکز تحقیقات ناباروری بود اما بعدا تحقیقات در حوزه سلول های بنیادی را آغاز کرد. اولین گزارش تولید سلول های بنیادی جنینی سال 2004 میلادی در پژوهشگاه منتشر شد.
وی افزود: به تدریج بحث کاربردی کردن دانش سلول های بنیادی مطرح شد که شاخهای جدید در پزشکی امروز است و پزشکی بازساختی نامیده می شود. در این دانش نوین با استفاده از دانش سلول های بنیادی و مهندسی بافت دو هدف اصلی دنبال می شود. هدف اول ترمیم بافت آسیب دیده است تا این بافت بتواند به فعالیت فیزیولوژیک خود برسد. هدف دوم تولید بافت، سلول یا اندام هایی است که بتوانند به صورت جایگزین پیوند شوند و آسیب را برطرف کنند.
عضو هیات علمی پژوهشکده سلول های بنیادی پژوهشگاه رویان ادامه داد: سابقه پژوهش های پزشکی بازساختی در پژوهشگاه رویان به 22 سال قبل بازمی گردد. پژوهشگاه مطالعات کارآزمایی بالینی را در این زمینه آغاز کرد. مطالعاتی که در این حوزه با استفاده از آزمایش روش های نوین درمانی روی بیماری های صعب العلاج یا لاعلاج انجام می شود پنجره امیدی برای درمان این بیماران باز می کند.
وی تاکید کرد: مطالعات در این زمینه در حوزه های مختلف پزشکی به طور مثال حوزه بیماری های مغز و اعصاب، بیماری های قلب و عروق، بیماری های استخوان، مفاصل و ارتوپدی، بیماری های پوست، بیماری های خودایمن شروع شد و حتی یک سری بیماری های مادرزادی نیز در این تقسیم بندی جای گرفت.
وثوق گفت: این مطالعات در فازهای اول، دوم، سوم و چهارم بالینی انجام و به تدریج در نشریات معتبر بین المللی و داخلی منتشر شد. این مطالعات با هدایت و تحت نظارت سازمان غذا و داروی وزارت بهداشت انجام می شود. سازمان غذا و دارو مستندات بالینی هر مرحله از مطالعه را بعد از پایان آن، بررسی و مجوز آغاز فاز بعدی را صادر می کند.
تولید داروهای ایرانی بیماریهای پوستی و مفصلی
وی در مورد نتایج دستاوردهای جدید این مرکز اظهار داشت: اکنون محصول بیماری پوستی ویتیلیگو به نام ریکالرسل را که فاز چهار آن را در دست داریم که در مرحله پست مارکت است. دو محصول دیگر شامل رنیودرم سل برای بیماری های پوست و مزستروسل برای بیماری های ارتوپدی، مفاصل و استخوان در فاز سه هستند. محصولات متعدد دیگری نیز در فازهای یک و دوم قرار دارند. مطالعات پست مارکت، مطالعاتی است که قبلا تایید گرفته و مطالعات بیشتر روی آنها برای جمع آوری اطلاعات بیشتر انجام میشود.
وثوق خاطرنشان کرد: از آنجا که فرایند معرفی یک محصول جدید و ارایه آن به بیماران برای مصرف بسیار پیچیده، زمانبر و طولانی است و گاهی ممکن است تا دهه ها طول بکشد، تولید محصولات متعدد دیگری نیز در دست انجام است که در فاز یک و دو هستند. همچنین برای چشم انداز آینده محصولاتی را در حوزه بیماری های تحلیل دهنده سیستم اعصاب مرکزی، بیماری های تحلیل دهنده سیستم قلب و عروق و بیماری های تحلیل دهنده سیستم تنفسی در دست داریم که به تدریج با طی شدن فازهای مطالعاتی معرفی خواهند شد.
عضو هیات علمی پژوهشکده سلول های بنیادی پژوهشگاه رویان در مورد حوزه مطالعاتی خود اظهار داشت: در حال حاضر روی پروژه استفاده از سلول های بنیادی در درمان بیماری های کبد و سیستم گوارش کار می کنم. این مطالعات با همکاری دانشگاه های علوم پزشکی سراسر کشور و به طور خاص مرکز کبد و گوارش دانشگاه های علوم پزشکی تهران و شهید بهشتی انجام می شود. با دانشگاه علوم پزشکی شیراز هم در این زمینه همکاری داریم.
وی در مورد خدمات ارایه شده در رویان خاطرنشان کرد که خدمات مبتنی بر پزشکی بازساختی در مرکز سلول درمانی رویان ارایه می شود. البته در حوزه های مختلف اقداماتی صورت می گیرد اما این حرکت نیاز به تقویت و توجه ویژه دارد.
مرکز جامع سلولهای بنیادی و پزشکی بازساختی رویان در سال 1398 تاسیس شد. ماموریت اصلی این مرکز تجمیع و یکپارچهسازی مراکز مختلف تحقیقاتی، تولیدی و فناوری پژوهشگاه رویان است تا پویاتر و پرشتابتر از پیش برای دستیابی به اهداف مجموعه از جمله تولید محصولات فناورانه در حوزه بیوتکنولوژی و بیولوژی، تولید محصولات به منظور کاربرد در بالین، کمک به درمان بیماریهای سخت و توسعه سلامت عمومی جامعه حرکت کند.
پزشکی بازساختی؛ انقلابی در دانش پزشکی
وثوق در مورد اهمیت پزشکی بازساختی عنوان کرد: این دانش جزو دانش های بسیار استراتژیک و کلیدی در جهان امروز است. کشورهای پیشرفته سرمایه گذاری های بسیار بزرگی در این زمینه انجام داده اند. آنها ضرورت پزشکی بازساختی را لمس کرده اند. با افزایش نسبی امید به زندگی و شایع شدن ناتوانی های جسمی در افراد سالمند ضرورت استفاده از پزشکی بازساختی خیلی بارز است، کشورهای توسعه یافته چون از نظر امید به زندگی شاخص های بالاتری دارند، زودتر به این حقایق رسیدند.
با بالا رفتن سن و پیری جمعیت آسیب پذیری در برابر مشکلات بهداشتی مرتبط با سن بیشتر می شود. در این شرایط با چالش جدی تری روبرو هستیم و آن کمبود فزاینده پزشک و پرستار است.
پیشرفتهای به دست آمده در دانش پزشکی عمر بیماران را افزایش داده ولی بیماریهای تحلیل رونده بافتی مثل بیماریهای قلبی ناشی از سکته، بیماریهای عصبی و بیماریهای استخوانی و غضروفی را نیز به دنبال داشته است. در این بیماریها عضو مبتلا بخشی از عملکرد خود را به علل مختلفی از دست میدهد، از عوامل موثر در این بیماریهایی کهولت سن، حوادث عروقی، تغذیه، عوامل محیطی و ژنتیکی است.
با بالا رفتن سن و پیری جمعیت که معضل بسیاری از کشورها از جمله کشورهای توسعه یافته است، افراد بسیاری در معرض بیماری هایی نظیر پوکی استخوان، نارسایی قلبی و بیماریهای مرتبط با فرسودگی و ازکارافتادگی انواع اندام های حیاتی قرار می گیرند.
با وجود این تحقیقات هنوز راه حل درمانی مناسبی برای این بیماریها یافت نشده است. دانش پزشکی امروز به دنبال توسعه علوم به صورت چند رویکردی است که پزشکی بازساختی یکی از مهمترین این رویکردها است.
ایران و غرب آسیا
در حال حاضر کاربرد طب بازساختی در بیماریهای زیادی مطرح شده و کشور ما نیز در این زمینه پیشگام است. ظرفیت های بزرگی در کشور در حوزه سلول های بنیادی و پزشکی بازساختی وجود دارد. علاوه بر آن با توجه به گسترش و رونق این رشته در آینده باید زمینه فعالیت در بازار جهانی را نیز فراهم کنیم.
رشد این دانش در ایران، به سلامتی هر چه بیشتر و نجات جان انسان ها کمک می کند و بازار کار بسیار وسیعی برای دانش آموختگان رشته های مختلف تحصیلات تکمیلی فراهم می آورد. همچنین درآمد ارزی قابل توجهی برای کشور در پی خواهد داشت.
وثوق در مورد پیشرفت پزشکی بازساختی در غرب آسیا نیز گفت: در این منطقه کشورهای ترکیه و عربستان شانه به شانه ما پیش می روند. این کشورها سرمایه گذاری های قابل توجهی انجام داده و تعاملات بین المللی تثبیت شده تری دارند. این در حالی است که کار در ایران زودتر شروع شد و جلوتر بود اما با توجه به شرایط بهتر این دو کشور از نظر ارتباطات بین المللی، وجود تعاملات و دانشگاه های معتبر، سرمایه گذاری در حوزه پژوهش، اعطای گرنت های پژوهشی برای محققان برتر، فراهم آوردن شرایط بهتر زندگی برای جذب محققان تراز اول دنیا و محققان بومی خود، اکنون روند و سرعت رشد این دانش در این کشورها از ما بهتر است.
وی در خصوص ظرفیت های پزشکی بازساختی در زمینه توریسم درمانی نیز گفت: در این حوزه می توانیم توریسم درمانی خیلی خوبی داشته باشیم. قبل از شرایط کرونا بیماران از کشورهای منطقه برای خدمات بهداشتی و درمانی به کشور ما می آمدند اما با شرایط کرونا محدودیت هایی ایجاد شده است. در حالی که در این حوزه می توانیم خیلی خوب کار کنیم.
عضو هیات علمی پژوهشکده سلول های بنیادی پژوهشگاه رویان آینده علم پزشکی را پزشکی بازساختی دانست و گفت: با اعتماد و اطمینان می گویم دانش سلول های بنیادی و پزشکی بازساختی انقلابی بود که در قرن اخیر اتفاق افتاد و می تواند راه حلی برای مشکلات آینده بشری باشد. تصمیم سازان و تصیم گیران نیاز دارند دانش خود را در این حوزه ارتقا دهند و ببینند دنیا به کدام سمت حرکت می کند. آنها باید از افرادی که در این زمینه تخصص دارند و عمرشان را گذاشته و مویی سفید کرده اند، استفاده کنند.
وی با انتقاد از افرادی که ادعای کارشناسی دارند اما عملا دانشی ندارند، افزود: در این زمینه باید از افراد صاحب نظر استفاده کنیم و نگاه ویژه ای به این حوزه داشته باشیم.
شرکتهای دانش بنیان صوری، آفت دانشبنیانها
وثوق همچنین خواستار حمایت از شرکت های دانش بنیان این حوزه شد و تاکید کرد: باید از شرکت هایی که استخوان خرد کرده اند و سابقه دارند حمایت شود تا بتوانند خدمت یا محصولی ارایه دهند. آفتی که دانش بنیان ها دارند این است که برخی صوری تشکیل می شوند فقط وام می گیرند، بدون طرح توجیهی و بدون اینکه محصولی مدنظرشان باشد و بعد از چند سال هم تعطیل می شوند.
وثوق گفت: کاری که مرحوم دکتر سعید کاظمی آشتیانی 32 سال پیش با بنیان گذاری پژوهشگاه رویان انجام داد و با سرعت قابل قبول و قابل توجهی پیش رفت، اکنون به علت محدودیت ها، ندیدن ها و توجه نکردن ها در حوزه های مختلف تبادلات علمی و تبادلات لجستیک، سرعت آن کند یا شاید حتی متوقف شده است و اگر به داد این حوزه نرسند، شاید تا چند سال دیگر حرفی برای گفتن نخواهند داشت.
پژوهشگاهها فقط توان پرداخت حقوق پایه را به پژوهشگران دارند / مهاجرت محققان افزایش یافته است
وی در مورد وضعیت بودجه پژوهشی نیز تصریح کرد: بودجه پژوهشی به علت مشکلات، تقریبا به صفر رسیده است. پژوهش خیلی جایگاهی ندارد. محققان خیلی خوب و تراز اول با توجه به شرایط اقتصادی و مشکلاتی که برای آنها ایجاد می شود، شاید انگیزه ماندن و کار کردن نداشته باشند؛ تعدادی هم که مانده اند، به علت سیستم فشل اداری، بوروکراسی و تحریم ها روزبهروز دلسرد می شوند و می روند. مراکز عمده پژوهشی نهایت هنرشان پرداخت حقوق پایه به پژوهشگران است و نمی توانند پروژه های کلان بردارند و کارهای بزرگ انجام دهند. محققان نیز نمی توانند خیلی از دانش خود استفاده کنند.
بازار بزرگ پزشکی بازساختی
بر اساس اعلام سایت بیزینس وایر، بازار جهانی طب بازساختی در سال 2021 میلادی 16.69 میلیارد دلار برآورد شد که انتظار می رود در سال جاری میلادی از 20 میلیارد دلار فراتر رود و تا سال 2027، با رشد سالیانه بیش از20 درصد به 49.94 میلیارد دلار برسد. برخی کارشناسان حتی پیش بینی می کنند که ارزش بازار این روش درمانی تا سال 2030 به 100 میلیارد دلار می رسد.
همچنین طبق اعلام سازمان اتحاد برای طب بازساختی که یک سازمان حمایتی بین المللی است، حدود هزار شرکت در سراسر جهان در زمینه توسعه فناوری ها و درمان های طب بازساختی فعالیت می کنند که بیشتر آنها در آمریکا قرار دارند. بسیاری از برنامه های تحقیقاتی بر بیماری های جدی متمرکز است که در یک جامعه سالمند و سایر حوزه های پزشکی تحقق نیافته تاثیرات فزاینده ای دارد.
در پنج سال گذشته شرکت های مهم بیودارویی قابلیت های عظیم طب بازساختی را دریافته اند. شرکت های بزرگ نیاز دارند که بی وقفه به رشد خود ادامه دهند و منابع خود را نوسازی کنند. وقتی رویکردهای نویدبخش ظهور می یابد، به تصاحب شرکت های بزرگتر که کانال های قویتری به بازار دارند، تبدیل می شوند.
از طرف دیگر، فناوری طب بازساختی نیازمند قابلیت های تخصصی مانند زنجیره سرد یا ذخیره و توزیع کرایوژنیک است. شرکت هایی که این چالش ها را حل کنند، از کانال های موثرتر و قویتری در بازار برخوردار می شوند.
فناوری های زنجیره تامین و قابلیت های توزیع با روش های نوین درمانی تطبیق می یابد. روش های سنتی لجستیک و زنجیره تامین دارویی برای روش های پیشرفته مناسب نیست.
طب بازساختی و سلول های بنیادی با سرعت بالایی در حال رشد است. غفلت از این حوزه باعث فاصله گرفتن جامعه علمی پژوهشی کشور از کشورهای توسعه یافته خواهد شد. اهمیت این موضوع زمانی مشخص می شود که دریابیم شرکت های تجاری مهمی در دهه اخیر به حوزه بازار طب بازساختی که سودآوری بالایی دارد، قدم گذاشته اند.
سلولهای بنیادی پرتوان القایی
ژاپن 970 میلیون دلار در طب بازساختی سرمایه گذاری و راهبرد خود را بر سلول های بنیادی پرتوان القایی متمرکز کرده است تا بر مشکل پیری جمعیت و حفظ رشد اقتصادی خود فائق آید. این سلول ها به ویژه برای ژاپن که کمترین میزان اهدای عضو را در کشورهای صنعتی دارد، جذاب است.
سلول های بنیادی پرتوان القایی (iPS: induced Pluripotent Stem cells) برای اولین بار در سال 2006 در دانشگاه کیوتو ژاپن توسط تیم تحقیقاتی Shinya Yamanaka شینیا یاماناکا تولید شدند. این سلول ها به علت توانایی خودنوسازی و همچنین تشکیل تمام ردههای سلولی بدن، امید زیادی برای درمانهای جایگزین سلولی ایجاد کرده اند.
تکنولوژی سلولهای iPS با استقبال زیادی در دنیای پزشکی بازساختی (Regenerative Medicine) و پزشکی شخصی (Personalized Medicine) همراه بوده است، زیرا در بیماری های زیادی به عنوان یک منبع سلولی مشتق از بیمار می توان از آن ها استفاده و مشکل رد ایمنی را مرتفع کرد. اهمیت بالینی سلول های iPS توسط گروه های تحقیقاتی مختلفی در سراسر جهان اثبات شده است.
سلول های بنیادی جنینی، سلول های بنیادی پرتوانی هستند که علاوه بر قابلیت خودنوزایی نامحدود، دارای توانایی تمایز بالا به دودمان های سلولی مختلف هستند که به این قابلیت، پرتوانی میگویند.
سلول های پرتوان القایی به سلول های بنیادی تمایز نیافته می گویند که اجزای سازنده بیشتر اندام ها است. سلول های بنیادی سپس برای ترمیم بافت انسانی یا رشد اندام ها مورد استفاده قرار می گیرند.
تحقیقات سلول های بنیادی پرتوان القایی در ژاپن بعد از آن که شینیا یاماناکا زیست شناس با کشف نحوه تبدیل سلول های خون یا پوست بالغ به سلول های بنیادی نابالغ که بعدا می توانند به سلول های ماهیچه قلب، غضروف، عضلات یا نرون ها تبدیل شوند، جایزه نوبل پزشکی را از آن خود کرد، کلید خورد.
سلول های پرتوان القایی نویدبخش درمان بیماری های نادر و لاعلاجی مثل ای ال اس یا لوگریگ و آلزایمر است.
دیوید سیرانوسکی پژوهشگر سیاست علوم در دانشگاه کیوتو می گوید: با وجود صدها کلینیک که در آمریکا درمان های اثبات نشده سلول های بنیادی ارائه می کنند، سازمان غذا و داروی این کشور فقط پیوند سلول های بنیادی خون برای سرطان ها و بیماری های سیستم ایمنی و خون را تایید کرده است.
وی می افزاید: در حالی که درمان با کمک سلول های پرتوان القایی امیدی برای آینده فراهم کرده است اما تایید آنها سال ها طول می کشد. استفاده از سلول های بنیادی دشوارتر از چیزی است که مردم فکر می کنند. این درمان ها هنوز خود را اثبات نکرده اند.
تسکین درد تا جایگزینی سلولهای آسیب دیده قلب
توماس شولر بنیانگذار موسسه نخاع ویرجینیا در رستون آمریکا می گوید: وقتی به گذشته پزشکی و نقاط عطف در این حوزه می نگرید، اشعه ایکس بیش از 100 سال است که کاربرد پیدا کرده است و هنوز هم با اهمیت است. اگر بازوی شما بشکند، آن را گچ می گیرید تا استخوان ترمیم شود و از بیولوژی بدن خود بیمار برای بهبودی استفاده می کنید. گچ گیری نیز بیش از 100 است که استفاده می شود.
وی می افزاید: نکته هیجان انگیز در مورد آینده دانش پزشکی این است که از بیولوژی بدن خود افراد برای درمان و التیام استفاده می کنیم. یعنی از طب بازساختی برای التیام آسیب دیسک، رباط و احیای عملکرد فرد بدون انجام عمل جراحی و با استفاده از بیولوژی بیمار بهره گرفته می شود.
شولر تاکید کرد: مخالفان بسیاری هستند که معتقدند طب بازساختی هنوز خود را اثبات نکرده اما بیش از یک دهه است که از این شیوه استفاده می کنیم و تغییر باورنکردنی در درمان بیماران مشاهده کرده ایم.
وی گفت: ما برای درمان کمردرد نمی خواهیم عمل فیوژن انجام دهیم، به جای آن مغز استخوان بیمار را می گیریم، آن را به دیسک تزریق می کنیم و بیمار زندگی و فعالیت عادی خود را از سرمی گیرد. طی پنج تا 10 سال آینده جامعه پزشکی بیدار خواهد شد و پی خواهد برد که چه پیشرفت باورنکردنی در استفاده از بیولوژی بدن بیمار برای درمان وجود دارد.
میزان موفقیت طب بازساختی حیرت انگیز است؛ این دانش به طور مداوم پالایش می شود و بهتر می شود. بیماران بیشتر و بیشتری با آگاهی از فواید این شیوه درمانی به این درمان ها روی می آورند. هیچ درمان دیگری وجود ندارد که بتواند بطور موثر درد را در تمام نقاط بدن برطرف کند و در عین حال کیفیت زندگی را بهبود بخشد.
طب بازساختی بارها نشان داده است که در رفع هرگونه درد از تمام محصولات عرضه شده در بازار بهتر است و نیاز به مراجعه مکرر به پزشک را برطرف می کند.
بازسازی سلول های استخوان در زانو زندگی دوباره ای به مفاصل و بدن می بخشد و با گذشت زمان درد برطرف می شود. آرتروز و درد مچ دست در بسیاری از افراد به ویژه کسانی که مدت زیادی با کامپیوتر کار می کنند، شایع است. درد مفاصل مشکلی شایع در افرادی است که سن آنها در حال افزایش است. این درد بر اثر آرتروز بروز می کند.
درد کشیدن در طول ماه ها و سال ها به سلامت جسمی و روانی آسیب می رساند و طب بازساختی به هر نوع دردی پاسخ می دهد.
طب بازساختی در درمان دیابت نوع یک، ترمیم بافت قلب و عروق، ترمیم بافت آسیب مغزی، بهبود سیستم ایمنی بدن، سلول درمانی، مهندسی بافت، برخی انواع سرطان ها، زخم های پوستی و پیوند عضو بسیار کاربرد دارد.
نارسایی قلبی، بیش از 97 میلیون انسان را درگیر کرده است که از این میان حدود 47 درصد مبتلایان، در مدت چهار سال بعد از تشخیص بیماری، جان خود را از دست می دهند.
در حالی که انواع زیادی تحقیقات طب بازساختی در دست انجام است، برخی به مرحله کاربردی رسیده است. یکی از آنها سلول درمانی است. دانشمندان سلول های بنیادی تخصصی را در آزمایشگاه رشد می دهند و بسته به نیاز، این سلول ها به برخی انواع سلول ها مثل سلول های قلب، خون یا اعصاب تبدیل می شوند. به طور مثال اگر بیماری قلبی داشته باشید سلول های عضله قلب ساخته شده در آزمایشگاه برای بافت پیوندی استفاده می شود تا به ترمیم یا جایگزینی سلول های آسیب دیده قلب کمک کند.
برچسبها